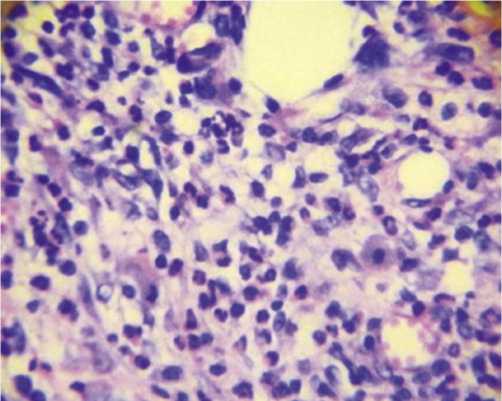

Принципы лечения посттравматических хронических ран
Автор: Левчук А.Л., Струков С.Ю., Игнатьев Т.И., Попова К.В., Гринь Н.А.
Журнал: Вестник Национального медико-хирургического центра им. Н.И. Пирогова @vestnik-pirogov-center
Рубрика: Оригинальные статьи
Статья в выпуске: 1 т.21, 2026 года.
Бесплатный доступ
Заживление раны представляет собой единый активный динамический процесс, который начинается с момента повреждения и заканчивается восстановлением целостности ткани. На основании совершенствования научных знаний и прогресса фармакологической индустрии появляется возможность внедрения хирургических методик и терапевтических мероприятий, которые окажут существенную поддержку собственным возможностям организма этой тяжелой категории пациентов по предупреждению развития и лечения длительно незаживающих хронических посттравматических ран. Цель: оптимизировать диагностические подходы и лечебный алгоритм у пациентов с хроническими ранами мягких тканей и оценкой их соответствия стандартам оказания медицинской помощи в многопрофильном стационаре. Материалы и методы: клиническое исследование основано на ретроспективном анализе результатов хирургического и медикаментозного лечения 82 пострадавших с хроническими посттравматическими ранами туловища и конечностей. Пациенты были разделены на две репрезентативные группы. В первой исследовательской группе (n = 32) местное лечение ран во II фазе раневого процесса проводилось с применением крема «Велстик-PRO», содержащего в своем составе препараты серебра и регенераторы роста эпителия. Вторая контрольная группа (n = 50) была разделена на две подгруппы (I подгруппа (n = 20) лечилась традиционными антисептиками, во II подгруппе (n = 30) перевязки осуществлялись с применением мази «Эбермин»). Результаты лечения в исследуемых группах оценивались по количественным (Визуальный скрининг, планеметрия и гистоморфология) и качественным (Бак. посев, сатурация в ране, индекс наполнения пульса, скорость изменения кровонаполнения капилляров) характеристикам на 3, 7, 15, 20 сутки течения раневого процесса. Результаты: воспалительная реакция тканей в первой группе значительно быстрее купировалась к 3-м суткам, а к 7-м начинался процесc с эпителизации хронических ран. Во второй группе этот срок был значительно дольше (в 2,5 раза). Наибольшее количество пациентов первой группы (82,4%) к 15-м суткам характеризовались полной эпителизацией ран или их подготовленностью к пластическим операциям, направленным на закрытие кожного дефекта. Во второй группе (особенно в I подгруппе) этот срок растягивался более 20 суток, а возможность выполнения пластических операций появлялась только через 27 суток у 43,5% больных. Заключение: местное применение крема «Велстик-PRO» позволяет оптимизировать репаративные процессы в ране в 2 раза быстрее по сравнению с традиционными медикаментозными средствами, что дает возможность рекомендовать его в лечебном алгоритме хронических посттравматических ран после их тщательной хирургической обработки во II и III фазах течения раневого процесса.
Хроническая посттравматическая рана, алгоритм и методы лечения
Короткий адрес: https://sciup.org/140314189
IDR: 140314189 | DOI: 10.25881/20728255_2026_21_1_106
Principles of treatment of post-traumatic chronic wounds
Wound healing is a single active dynamic process that begins at the moment of injury and ends with the restoration of tissue integrity. Based on the improvement of scientific knowledge and the process of the pharmacological industry, it is possible to introduce surgical techniques and therapeutic measures that will provide significant support to the body’s own capabilities of this severe category of patients to prevent the development and treatment of long-term non-healing chronic post-traumatic wounds. Objective: to optimize diagnostic approaches and treatment algorithm in patients with chronic soft tissue wounds with an assessment of their compliance with the standards of medical care in a multidisciplinary hospital. Materials and methods: the clinical study is based on a retrospective analysis of the results of surgical and medical treatment of 82 patients with chronic wounds of the trunk and limbs. The patients were divided into two representative groups. In the first research group (n = 32), local wound treatment in phase II of the wound process was carried out with the use of Velstic-PRO cream, which contains silver preparations and epithelial growth regenerators. The second control group (n = 50) was divided into two subgroups (subgroup I (n = 20) was treated with traditional antiseptics, in subgroup II (n = 30) dressings were changed using Ebermin ointment). The results of treatment in the study groups were evaluated by quantitative (visual screening, planometry and histomorphology) and qualitative (bacterial culture, saturation in the wound, pulse filling index, rate of change in capillary blood filling), characteristics of the course of the wound process on days 3, 7, 15, 20. Result: the inflammatory reaction of tissues in the first group was stopped much faster by the 3rd day, and by the 7th day, the process of epithelialization of chronic wounds began. In the second group, this period was much longer (2.5 times). By the 15th day, the largest number of patients in the first group (82.4%) were characterized by complete epithelialization of wounds or their preparedness for plastic surgery aimed at closing the skin defect. In the second group (especially in the first subgroup) this period lasted more than 20 days, and the possibility of performing plastic surgery appeared only after 27 days in 43.5% of patients. Conclusion: topical application of the cream (Velstic-PRO) allows you to optimize the reparative processes in the wound 2 times faster compared to traditional medications, which makes it possible to recommend it in the therapeutic algorithm of chronic post-traumatic wounds after their thorough surgical debridement in the II and III phases of the wound process.
Текст научной статьи Принципы лечения посттравматических хронических ран
Процесс заживления раны представляет собой естественный биологический феномен. Лечение ран на протяжении всей истории цивилизации не теряет своей медицинской и социальной значимости. Экономический и технический прогресс, происходящие военные конфликты и катастрофы в целом вовсе не гарантируют избавление человечества как от природных, так и от тех- ногенных факторов, способных вызвать тяжелые повреждения. Кроме того, целый ряд хронических заболеваний, осложняющихся хроническими вялотекущими ранами, таких как: сахарный диабет, хроническая сосудистая, ревматологическая, онкологическая и неврологическая патологии, имеют тенденцию к росту [1; 2].
В процессе лечения хронических ран организм действует по достаточно стандартной схеме, которая

начинается со свертывания крови, образования струпа, очищения раны от погибших тканей, инородных тел и микроорганизмов, и наконец, формирует для заполнения дефекта новую грануляционную ткань, которая со временем преобразуется и способна выполнять все функции, присущие кожным покровам. Эта цепочка взаимосвязанных биологических процессов предъявляет высокие требования к репаративным способностям организма, которые проявляются не только местно, но и затрачивают все резервы организма в целом [3].
Пока еще далеко не все известно о тонких механизмах процесса заживления ран, что создает трудности при лечении, особенно в случаях нарушения динамики их заживления. Однако на основе современных знаний можно построить такие хирургические методики и терапевтические мероприятия, которые окажут существенную поддержку собственным возможностям организма по восстановлению целостности кожного покрова [4; 5].
Вторично заживающая рана, которая, несмотря на адекватную терапию, в течение 8 недель не проявляет тенденции к заживлению, – считается хронической [7; 8]. Хронические посттравматические раны наиболее часто развиваются из острых ран в результате нераспознанной персистирующей инфекции или неадекватной первичной хирургической обработки [8]. Однако в большинстве случаев хронические раны представляют собой последнюю стадию далеко зашедшего разрушения тканей, вызванного сосудистыми заболеваниями венозного, артериального или обменного характера, лучевыми или опухолевыми поражениями [9].
Чаще всего хроническими кожными язвами страдают люди пожилого возраста. Тенденция к увеличению процента популяции пожилого возраста (в три раза!) будет в будущем еще больше привлекать внимание врачей всех специальностей к этой проблеме. Лечение хронических ран и язв кожных покровов предъявляет высокие требования к профессиональным навыкам и знаниям врача, занимающегося лечением этой сложной патологии. Современный уровень знаний о патофизиологии нарушенного заживления ран вполне может служить базой для их успешной терапии. Определен ряд эндогенных и экзогенных факторов, препятствующих репаративному процессу заживления, которые можно устранить или компенсировать с помощью правильного ухода за раной. Однако надо заметить, если в отношении дефиниции этого процесса многое становится на свои места, то рекомендации применительно к лечебно-диагностической тактике представляются разноречивыми, заоблачными, отстраненными, а иногда – бесполезными в обычной хирургической практике. Таким образом, формулировка и систематизация принципов лечения хронических ран требуют пересмотра и внедрения в практическую деятельность, с учетом появления новых фармакологических средств отечественного производства для лечения хронических ран.
Цель исследования
Оптимизировать диагностические подходы и лечебный алгоритм у пациентов с хроническими ранами мягких тканей с оценкой их соответствия стандартам оказания медицинской помощи в многопрофильном стационаре.
Материалы и методы
Наличие любой раны побуждает к естественному стремлению ликвидировать ее прежде всего путем хирургического вмешательства, что на практике реализуется методичностью, составляющей идею первичной или вторичной хирургической обработки ран. Однако, этот принцип не всегда приносит успех в лечении хронических вялотекущих посттравматических ран с присоединившейся инфекцией, среди которой особую опасность представляет «дремлющая» инфекция, агрессивность которой обуславливается метаморфозностью микробной флоры и реактивностью организма. В обоих случаях программа лечения должна состоять из двух принципов: ликвидации инфекции и создания протекции раневого процесса, с целью обеспечения оптимального и быстрейшего заживления. Это достигается путем применения современных медикаментозных принципов местного и общего воздействия на основные звенья патогенеза образования хронических ран: нарушение кровоснабжения тканей в результате снижения притока крови и доставки в них кислорода, шунтирование с извращением микроциркуляции, снижение венозного и лимфатического оттока, метаболические и обменные нарушения, инфекционные и аутоиммунные патологические процессы.
Клиническая работа была основана на ретроспективном анализе и рандомизированном, одноцентровом исследовании результатов хирургического и медикаментозного лечения посттравматических хронических ран мягких тканей туловища и конечностей у 82 пациентов, проходивших лечение в «НМХЦ им. Н.И. Пирогова» с 2020 по 2025 гг. Женщин было 59,8% (n = 49), мужчин 40,2% (n = 33), средний возраст составил 57 лет. Все исследуемые пациенты были разделены на 3 репрезентативные группы: основную (исследовательскую) группу составляли 32 пациента (39%), которым местное лечение хронических ран осуществлялось во II фазе течения раневого процесса с применением косметологического крема «Велстик – PRO» (Россия), содержащего в своей основе препараты серебра, сульфаниламиды и регенераторы роста эпителия. Инновационный препарат, созданный на основе новейших биотехнологий, активирует пролиферацию и миграцию кератиноцитов, фибробластов, макрофагов и эндотелиальных клеток, в результате чего быстро снижается воспаление, предотвращается вторичное инфицирование раны, и под их воздействием происходит краевая эпителизация и эстетичное рубцевание раневого дефекта на поверхности тела.
Контрольная группа – 50 пациентов (60,9%) были разделены на две подгруппы по 25 больных. В I подгруппе

Рис. 1. Хроническая рана черного цвета после элетротравмы (3 x 2 см).

контроля (n = 20–24,4%) пациенты получали традиционное медикаментозное местное лечение водорастворимыми мазями (Левосин, Левомеколь), во II подгруппе контроля (n = 30–36,6%) больным осуществлялось ведение хронических ран с применением эпидермального фактора роста с сульфадиазином серебра (мазь «Эбермин»). В ранее опубликованных научных работах нами уже указывалось на высокую эффективность этого препарата при лечении острых (свежих) и огнестрельных ран [10; 11]. Однако, их применение в местном лечении хронических посттравматических ран и трофических язв не рассматривалось, а результаты использования крема «Велстик – PRO» в изученной нами медицинской литературе вообще отсутствуют. Этот факт явился поводом к данному клиническому исследованию рандомизированных групп пострадавших. Пациенты всех когорт были сопоставимы по полу, возрасту, тяжести осложнений, а также по локальному состоянию ран (этиологическому фактору, площади раневых поверхностей, глубине поражения, микробному обсеменению, наличию некрозов и грануляций, длительным сроком (более 8 недель) отсутствия процессов регенерации и заживления).
Скрининговая и первоначальная классификация ран осуществлялась наиболее простым и вместе с тем удобным методом – разделение по их цвету [12]. Внешний вид хронической раны, описанный и фотодокумен-тированный по цветовой гамме, позволяет достаточно достоверно определять стадию раневого процесса, оценить его динамику, разработать программу местного лечения раны до получения результатов бактериологических исследований и применения комплекса инструментальных исследований (компьютерная томография, рентген, УЗИ, допплерография, ангиография и т.д.). Раны черного (Рис. 1) и темного (Рис. 2) цветов соответствовали I стадии раневого процесса, однако в первом случае обычно имеется сухой некроз, а во втором – влажный. Наличие красной (Рис. 3) раны свидетельствует о переходе раневого процесса во II стадию регенерации. Белая (Рис. 4) рана определяется при эпителизации раневого дефекта, что соответствует III фазе течения раневого процесса.

Рис. 2. Хроническая рана желтого цвета после автотравмы.

Рис. 3. Хроническая рана красного цвета после огнестрельного ранения.

Рис. 4. Хроническая рана белого цвета после вскрытия флегмоны с эпи-телизацией раневого дефекта.
Черная хроническая рана (эпидермальный некроз) наиболее часто возникала при некрозе тканей в результате травмы, инфекционных и иммунно-аллергических процессах, электроожогах с нарушением кровообращения. Поэтому некротический струп не подвергался самостоятельному отторжению в течение 3-х недель, а растягивался на многие месяцы. Наиболее эффективный и разумный способ ведения черной раны – сочетание хирургической и аутолитической некрэктромии (Рис. 5 и 6). Однако формирование черных ран на фоне острой и хронической критической ишемии тканей (гангрена или язва) не позволяет применить некрэктомию до ликвидации

Рис. 5. Хроническая рана после вторичной хирургической обработки.

Рис. 6. Хроническая рана после аутолитической некрэктомии.

Рис. 7. Хроническая серая рана с бактериальными биопленками.

явлений критической ишемии, острого инфекционного процесса и появления демаркационной границы некроза со здоровой кожей.
Желтая или серая хронические раны обычно характеризуются гидратированной поверхностью с обильным раневым экссудатом, фиброзными наложениями и бактериальными биопленками (Рис. 7). Главными задачами в лечении желтых хронических ран являются: подавление инфекции в ране, активация процессов отторжения нежизнеспособных тканей, эвакуация раневого содержимого с абсорбцией продуктов микробного и тканевого распада. Именно в лечении таких ран широко применяется методика управляемого отрицательного давления.
Белая хроническая рана относится к заключительной стадии заживления раневого дефекта посредством эпителизации его поверхности (Рис. 8). Основные задачи лечения такой раны сводятся к необходимости сохранения достаточного увлажнения и оксигенации раневой

Рис. 8. Краевая эпителизация хронической раны с местным применением гидрогелевой повязки.
плоскости, атравматичности смен повязок на гидрогелевой и гидроцеллюлярной основе. Общее стандартное лечение посттравматических хронических ран включает: антибактериальную, противовоспалительную, детоксикационную и инфузионную терапию.
В последние годы стратегически изменился подход к лечению хронических ран различного происхождения [13; 14]. Основной смысл данной стратегии состоит в хирургической обработке основания и фенотипически измененных краев раны с целью перевода ее в острую, которая достигается следующими тактическими подходами: тщательной хирургической санацией дна раны, контролем инфекции и воспаления, регулированием экссудации, ревизией состояния краев раны и стимуляцией эпителизации. Крайне важно учитывать нейро- и ангиоспастические факторы, сопутствующие течению раневого процесса, которые при вялотекущем, затяжном и хроническом характере заживления раны, – подчас имеют первостепенное значение и требуют соответствующей этиотропной терапии при сахарном диабете, облитерирующем атеросклерозе и эндартериите, хронической венозной недостаточности, пролежнях, лучевых и ожоговых поражениях и онкологической патологии.
Все статистические данные были обработаны с помощью компьютерной программы SPSS 23.0. Основные статистические характеристики представлены: М- среднее, S- стандартное отклонения, n- объём выборки, достоверность различием на уровне р≤0,05.
Результаты и обсуждения
Обработка раневой поверхности хронических ран с активным удалением некротических тканей, фибриновых наложений, инородных тел, участков гиперкератоза, – являлась основной лечения пациентов всех групп. В нашей клинической практике у 78% исследуемых применен хи-

Рис. 9. Метод ультразвуковой кавитации в лечение хронической раны.
рургический, в 7% химический (аутолитический) и 15% физический виды обработки поверхности раны. Наиболее эффективными являлись комбинированные методы обработки раны, которые применялись последовательно в 63% случаев на разных этапах лечения.
В патогенезе формирования хронических ран большое значение придают бактериальным биопленкам, которые представляют собой особое сообщество микроорганизмов различных видов (Табл. 1), живущих в межклеточном пространстве в виде мукополисахаридного матрикса. Биопленки существенно (до 78%) сдерживают развитие репаративных процессов у больных с хроническими ранами, а у иммуно- компроментиро-ванных больных в 43% приводят к развитию серьезных инвазивных инфекций, вплоть до возникновения сепсиса. Борьба с биопленками – достаточно сложный процесс многокопонентного воздействия на рану, который заключается не только в разрушении самой биопленки, но и создании неблагоприятных условий для ее повторного образования. Основой ликвидации биопленок в нашем исследовании являлась адекватная обработка раневой поверхности с привлечением методов ультразвуковой кавитации (Рис. 9), гидрохирургической (Рис. 10) и вакуумной обработки раны (Рис. 11). Местно использовали средства, содержащие серебро (Эбермин, Велстик – PRO) (Рис. 12). Промывание и обработка ран осуществлялась препаратом «Пронтосан», содержащий мощный нетоксический антисептик полигексанид и поверхностно – активное вещество. Следует отметить, что для лечения хронических ран нами использовались антибактериальные препараты, способные проникать в мукополисахаридный матрикс бактериального вещества: карбопенемы, линозолит, це-фазолин, фторхинолоны, аминогликозиды.
Поддержание влажной раневой среды являлось основополагающим моментом в процессе отторжения некрозов и улучшения условий для формирования гранул-ляционной ткани в раневой поверхности. Эффективная миграция эпителиоцитов, приводящая к заживлению раны, происходит только во влажной среде. При слабой

Рис. 10. Метод гидрохирургической обработки хронической раны.

Рис. 11. Метод вакуумной хирургической обработки хронической раны.

Рис. 12. Обработка хронической раны препаратом «Велстик-PRO».
экссудации, которая характерна для хронических ран, необходима дополнительная регидратация раневой поверхности, которая достигалась использованием гидрогелей, гидроколлоидов и гидроцеллюлярных антравматичных повязок.
При обширных и резистентных к различным видам местной терапии ранам (9%) мы стремились осуществить
раннюю кожную пластику, выбор метода которой зависел от размера, локализации, формы раневого дефекта, состояния микроцеллюлярного русла и наличия микробного пейзажа в области раневого ложа, общего состояния больного и тяжести сопутствующей патологии.
Основной конечной точкой исследования являлась скорость заживления кожного покрова и снижение воспаления в зоне повреждения под влиянием исследуемого крема «Велстик – PRO». Для объективизации исследования процесса репаративной регенерации в ране и реактивных изменений в организме исследуемых проводили: планеметрическое и гистоморфологическое исследование, бактериологический контроль раневой поверхности и определение маркеров воспаления (Прокальцитонин, С-реактивный белок, лейкоцитарный индекс интоксикации (ЛИИ)). Планиметрическое исследование заживления раны осуществлялось микроскопически: зону дефекта фотографировали в контрольных временных точках с последующей планиметрической обработкой фотографий в программе ImagaJ (NIH, США). В каждой контрольной точке измерений площадь дефекта (мм2), значение которой использовали для расчета степени замкнутости раны, как отношения площади закрытого (заэпителизированного участка раны) к ее начальной площади, выраженного в процентах (Рис. 13).
С целью гистологического исследования регенерата из каждой группы исследуемых в контрольных временных точках вырезали кожный околораневой лоскут, охватывающий поврежденные и интактные участки. После фиксации материала в 10% нейтральном буферном растворе формалина и дегидратированном спирте, его заливали в парафиновые блоки. Гистоморфометрию проводили в программе Slide Viewer 2.7 (Венгрия).
На гистотопограммах измеряли линейные размеры дефекта (мм). Площадь раны определяли как участки дермы и гиподермы непосредственно под повреждением и в зонах новообразованной эпителиальной ткани. Интенсивность воспалительного процесса оценивали полуколичественным методом по 4-бальной шкале: 0 баллов – отсутствие воспаления, 1–4 балла – рана инфильтрирована воспалительными клетками (на 1 балл ≤25%, 2 балла – 25–50%, 3 балла – 50–75%, 4 балла – >75% ее площади). Гемограмму с лейкоформулой и расчетом ЛИИ определяли с помощью гистологического анализатора VRIT-3020 (Китай).
Фиксация изменений состояния ран во всех группах пациентов проводилась не только по динамике их размера фотографированием, но и определялась качественная характеристика раневого процесса путем изменения дистанционной температуры и pH – метрии. Непосредственно с раны снимались показатели лазерными датчиками с помощью прибора с программным обеспечением «Ангиокод 322» (Рис. 14), по следующим параметрам: сатурация в ране, индекс отражения, индекс наполнения пульса, момент наибольшей скорости изменения кровонаполнения капилляров. Измерение показателей проводилось сразу

Рис. 13. Определение степени закрытия раны.

Рис. 14. Прибор «Ангиокод-322» с датчиками определения качественных характеристик хронической раны.
после удаления детрита с поверхности хронической раны, а также каждые 2-е суток до их полной эпителизации или пластики. После измерения качественных параметров ран, выполнялись перевязки с нанесением различны лечебных препаратов в группах исследования. Перевязки проводились ежедневно с очисткой раны и нанесением нового слоя исследуемых средств. Основные параметры показателей качественных и количественных изменений в течении раневого процесса во всех группах больных регистрировались в течение 3-х недель комплексного лечения (Табл. 1).
Табл. 1. Показатели качественной характеристики тканей хронических ран в исследуемых группах
|
Группы пациентов и параметры исследования |
Дни исследования |
|||
|
3 сутки |
7 сутки |
15 сутки |
20 сутки |
|
|
1. Сатурация раны (%) I группа |
87,55 |
89,85 |
91,79 |
98,61 |
|
II группа |
64,30 |
71,14 |
78,17 |
79,86 |
|
2. Индекс отражения I группа |
84,47 |
103,51 |
105,31 |
109,72 |
|
II группа |
72,27 |
93,21 |
95,93 |
101,14 |
|
3. Индекс наполнения пульса I группа |
3,33 |
2,711 |
2,37 |
1,96 |
|
II группа |
1,91 |
2,93 |
3,29 |
4,63 |
|
4. Момент наибольшей скорости изменения кровонаполнения капилляров I группа |
64,75 |
73,75 |
52,61 |
51,18 |
|
II группа |
146,25 |
78,16 |
88,32 |
102,75 |
Высокие показатели сатурации раны свидетельствуют о качестве ангиогенеза, прорастании сосудов и их кровенаполнении. Индекс наполнения пульса отражает происходящий ангиогенез на фоне стимуляции медикаментозными препаратами. Индекс отражения показывает артериальный тонус сосудов. Низкие показатели момента наибольшей скорости изменения кровонаполнения капилляров совместно с индексом пульсовой волны свидетельствуют о положительном эффекте использования местных медикаментозных средств в лечении хронических ран.
Необходимо подчеркнуть важность идентификации возбудителей пиогенных инфекций, поддерживающих гнойный процесс в хронических ранах и трофических язвах. В нашем исследовании у 74% пациентов в бактериограммах высевали грамположительные стафилококки и стрептококки, в 10% – грамотрицальные Pseudomonas и Escherichia coli. По цвету и характерному запаху экссудата ран предварительно определяли преобладающих тип возбудителя (стафилококки: сливочно-желтый гной без запаха; стрептококки: жидкий, желто-серый гной; синегнойная палочка – сине-зеленый гной со сладковатым запахом; кишечная палочка – коричневый гной с фекальным запахом). Однако, выбор целенаправленной антибиотикотерапии всегда основывался на результатах бакпосевов из ран и антибиотикограммах. Решающее значение имеет также число исходно попавших микроорганизмов на раневой поверхности. Измерение в стандартизированных пробах показало, что для развития и поддержания раневой инфекции необходимо 104 гноеродных стафилококков на мм3 или 106 Staphylococci aurei на мм3. В зависимости от клинического состояния пациентов считаем уровень 105 микроорганизмов на мм3 ткани установленным порогом, выше которого рассматривается необходимость применения антибиотикотерапии при инфекционных осложнениях хронических ран. Кроме патогенности в этой ситуации необходимо учитывать и степень вирулентности возбудителя, которые обладают резистентностью к терапии химическими препаратами (16%).
При местном применении крема «Велстик-PRO» после выполнения вторичной хирургической обработки ран у пациентов I группы было выявлено на 3-и сутки отсутствие гиперемии и отека краев раны (Рис. 15), в отличие от конкурентных средств, где эти визуальные параметры воспаления присутствовали. Исследования показателей сатурация в ране, индексов отражения и наполнения пульса, момента наибольшей скорости изменения кровонаполнения капилляров у пациентов I группы значительно превосходило эти значения у исследуемых II группы (с более значимой разницей в I подгруппе). К 7-ым суткам от момента лечения наибольшее сокращение площади раны отмечено в исследуемой I группе, которое составило 5314±34,2 мм2 тогда как в контрольной II группе этот показатель был значительно хуже (9697±15.8 мм2). К 15-м суткам лечения констатированы

Рис. 15. Вид хронической раны на 3-и сутки местного применения «Вел-стик-PRO».
Табл. 2. Площадь хронических ран в исследуемых группах в процессе лечения (мм2, М±S)
|
Дни исследования |
Группы пациентов |
||
|
I исследовательская группа (n = 32) М1±S |
II контрольная группа (n = 50) |
||
|
I подгруппа (n = 20) М2±S |
II подгруппа (n = 30) М3±S |
||
|
3 день |
10872,3±3,1 |
10914±1,4 |
10814±1,4 |
|
Р |
М1–М2<0,05 М2–М3<0,05 |
М1–М3<0,05 |
|
|
7 день |
5314±34,2 |
9697±15,8 |
7193±6,8 |
|
Р |
М1–М2<0,05 М2–М3<0,05 |
М1–М3<0,05 |
|
|
15 день |
872±27,9 |
9171±19,7 |
3942±5,3 |
|
Р |
М1–М2<0,05 М2–М3<0,05 |
М1–М3<0,05 |
|
|
20 день |
0 |
6432±5,6 |
1872±3,1 |
|
Р |
М1–М2<0,05 М2–М3<0,05 |
М1–М3<0,05 |
|
Табл. 3. Индекса заживления хронических ран в исследуемых группах (%, М±S)
|
Группы пациентов |
Дни исследования |
|||
|
3 сутки |
7 сутки |
15 сутки |
20 сутки |
|
|
Исследовательская группа (I): |
15,42±0,62 |
20,14±3,1 |
17,21±0,07 |
21,64±0,11 |
Контрольная группа (II):
|
I подгруппа: |
0,15±0,02 |
7,2±0,17 |
5,3±0,11 |
5,6±0,17 |
|
II подгруппа: |
6,72±0,32 |
9,14±0,24 |
14,01±0,21 |
14,73±0,14 |
Примечание : (М1–М2<0,05; М1–М3<0,05; М2–М3<0,05).
весьма значительные различия этих показателей в исследуемой и контрольных группах (Табл. 2), что подтверждено динамикой индекса заживления (Табл. 3).
По данным гистограмм (Рис. 16, 17) более раннее формирование зрелой грануляционной ткани, наблюдаемое исследуемых I группы, а также миграция и пролиферация кератиноцитов и фибробластов под воздействием крема «Велстик-PRO», были связаны с увеличением экс-
Рис. 16. Гистограмма хронической раны на 7-е сутки лечения: граница раневого дефекта и зоны пролиферации кератиноцитов с нарастанием эпителиального пласта.

Рис. 17. Гистограмма хронической раны на 15-е сутки лечения: восстановление придатков кожи и полное закрытие раневого дефекта.
прессии и секреции основного фактора роста фибробластов и гидроксипролина в результате активации серици-ном синтеза коллагена. При этом стимуляция миграции клеток вела к формированию более толстого эпидермиса с минимальным иммунным ответом, что создавало более благоприятные условия для нарастания эпидермального пласта и закрытия раневых кожных дефектов у представителей I клинической группы. Процесс пролиферации и адгезии клеток с элиминацией активных форм кислорода играл важную роль в заживлении ожогов, длительно не заживающих ран и трофических изъязвлений.
На основании исследования динамики бактериологических посевов из ран выявлена мощная натуральная антимикробная активность препарата «Велстик-PRO», не уступающая эпидермальному фактору роста с сульфадиазином серебра (мазь «Эбермин»), против грамположи-тельных и грамотрицательных бактерий, что является значительным подспорьем для процесса репаративной регенерации во II фазе течения раневого процесса.
Табл. 4. Результаты лечения хронических ран в исследуемых группах (абс., %)
|
Группы пациентов |
7 сутки |
15 сутки |
20 сутки |
25 сутки |
||||
|
Исследовательская группа (I) (n = 32) |
Э |
П |
Э |
П |
Э |
П |
Э |
П |
|
Контрольная |
2 |
3 |
9 |
2 |
9 |
7 |
– |
– |
|
группа (II) (n = 50) |
6,25 |
9,38 |
28,13 |
6.25 |
28,13 |
21,88 |
||
|
I подгруппа |
– |
– |
4 |
3 |
1 |
2 |
4 |
6 |
|
(n = 20) |
20 |
15 |
5 |
10 |
20 |
30 |
||
|
II подгруппа |
1 |
5 |
3 |
9 |
7 |
1 |
4 |
|
|
(n = 30) |
3.33 |
16,7 |
10 |
30 |
23,3 |
3,33 |
13,3 |
|
Примечание : «Э» – эпителизация раны; «П» – подготовка раневой поверхности к пластике.

Рис. 18. Алгоритм лечения хронических посттравматических ран.
Таким образом, результаты исследования (Табл. 4) и их сравнительная оценка указывают, что при комплексном применении крема «Велстик-PRO» течение раневого процесса было значительно лучше, что позволило добиться заживления и эпителизации хронических посттравматических ран к 20-му дню его применения за счет значительного (в 3 раза) сокращения продолжительности II и III фаз течения раневого процесса. Аппликация крема приводит к быстрому снижению гнойно-воспалительной экссудации и ускорению восстановления кожного покрова. Лечебный эффект крема «Велстик – PRO» идентичен с таковым у зарегистрированного лекарственного препарата «Эбермин», содержащий эпидермальный фактор роста и сульфадеазин серебра, доказавшего свою эффективность и безопасность. Это дает основание рекомендовать его использование в качестве самостоятельного лекарственного препарата в форме крема в клинической практике лечения хронических ран с патологической регенерацией.
При обширных кожных дефектах и при посттравматических ранах, резистентных к различным методам
местной терапии, следует рассматривать вопрос о проведении ранней кожной пластики, выбор метода которой зависит от размеров, локализации, формы раны, состояния микроциркуляции в области раневого ложа, общего состояния больного и тяжести сопутствующей патологии. Следует отметить, что общие принципы лечения хронических посттравматических ран должны быть едины, не взирая на их этиологию, а лечебная тактика местной терапии должна определяться фазой раневого процесса и его особенностями (Рис. 18). Только дифференцированный подход и направленное воздействие на раневой процесс на различных этапах лечения ран, с учетом индивидуальных особенностей их течения, позволяет добиться основной цели – избавления больного от раневого дефекта, существующего порой не один месяц и год.
Заключение
Хроническая посттравматическая рана по своей сути представляет собой вторично заживающую острую рану, срок эпителизации которой превышает 8 недель. Переход от острой раны к хронической может произойти на любой из фаз заживления. Однако большей частью хронические посттравматические раны развиваются на почве далеко зашедшей альтерации тканей, связанных с нарушением их кровоснабжения, регенерации и вирулентной инфици-рованностью. Использование предложенного алгоритма лечения хронических ран в симбиозе с применением современных мазевых препаратов фактора роста и аппликационных повязок несомненно улучшат результаты лечения этой сложной категории пациентов.
Современное лечение хронических посттравматических ран должно осуществляться комплексно, с коррекцией соматического состояния пациента и адекватной местной терапией при использовании современных средств обработки раневых дефектов в строгом соответствии со стадийностью раневого процесса. Это позволяет более широко применять консервативное лечение больных с обширными вялотекущими гнойно – некротическими процессами, использовать ранние операции по закрытию тканевых дефектов, добиваться регенерации без формирования грубой рубцовой ткани, значительно улучшая уровень и качества жизни пациентов.


